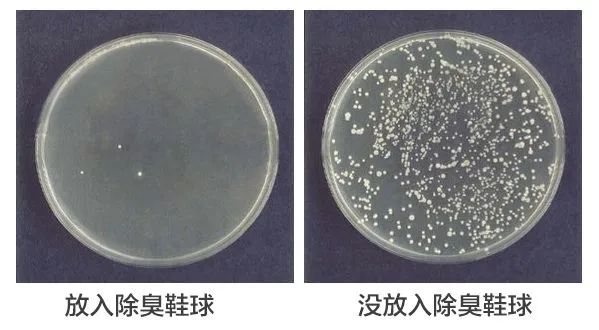
放上这颗球，再也不用担心进屋不敢脱鞋了

对于脚臭的人,以下这些最日常不过的瞬间,简直就是公开处刑:
| 去朋友家做客,脱鞋进门的瞬间,主人微微皱眉。
| 和客户去吃日料,脱鞋落座,客户全程皱着鼻子,突然推辞离开。
| 坐火车卧铺,一脱鞋,连乘务长都说:“小伙子,快盖好你的脚”。

无论你是貌比潘安,还是才高八斗,一旦被贴上“这人脚臭”的标签,就难逃被人背后议论的命运。
要论尴尬程度绝对可以排进人生前三位。
为了解决脚臭,各种方法更是应运而生,最常见的莫过于:泡脚~

然而热爱泡脚的人很多,但口味配方却大不同。
从最开始的加花瓣,加香料,到后来加茶叶,加料酒,最后还有人加醋,加生姜,加大蒜......花式泡脚。
但实际上通过泡脚来除脚臭,并没啥用,杀菌力还不如用肥皂洗,顶多更像是酱!猪!蹄!

其实脚臭的根本原因在于:脚汗+细菌=脚臭。
脚汗本身是没有味道,但是被细菌分解后,就会产生有挥发性的支链不饱和脂肪酸等物质,通俗地说就是我们闻到的类似臭鸡蛋的脚臭味。

因此想要真正除脚臭,不仅要关注脚本身的洁净,如勤洗脚, 剪指甲,更要除菌。
而我们穿的鞋子就像是一个霉菌螨虫细菌的大型繁殖皿,密闭潮湿,简直是细菌的天堂~

每次为了除脚臭,各种洗脚、修甲、涂药膏,把脚打理得干干净净,结果天天还是穿着一双臭鞋,前功尽弃。
而且想想你的脚一天有大半的时间,都包裹在这样的细菌繁殖皿,不止脚气,瘙痒、脱皮、鸡眼、灰指甲……都找上门。
| 想想你有多久没洗鞋?还是从不洗?
| 雨天打湿不晾干,随手放鞋柜?
| 梅雨季任由其放在潮湿鞋柜?
想要除脚臭,鞋子除菌第一步!
今天小僵尸就要给大家推荐一款好用不贵、植物成分、强效杀菌的鞋子除臭克星:
Clean-n-Fresh除臭鞋球
点击下面小程序即可购买
相比于市面上的鞋子除臭产品,这款除臭鞋球可以说深得我心。
方便好用,不伤鞋,除了给鞋子除臭杀菌,还能用在其他方面,一物多用,简直吹爆。
推荐理由:
1.植物源头性除臭,杀菌率高达99%。
2.小巧放置型除臭,方便不伤鞋。
3.国际大牌香调,散发沁人清香。
4.汽车、厕所、衣柜、杂物篮多场合使用。
5.美国大品牌,好用不贵,单颗可用45天。
比活性炭还强的植物除味
抑菌率高达99%
目前市面上的鞋袜除臭产品,大多都是粉状和*剂喷**。
用起来就知道有多麻烦,药粉用完还要清理鞋内的粉末,喷雾则会弄湿鞋子,遇上阴雨天还晾不干。

还有一些除臭剂只是用香味暂时覆盖,无法从根源杀菌除味,一上脚该臭还是臭。

关键是鞋内细菌不除,发霉发臭都算小事。
想象一下生活在鞋子里成千上万的细菌在你潮湿闷热的双脚吃喝拉撒,不停蠕动,繁殖,无穷无尽~

各种脚部问题找上门,像脚气就是真菌感染,一穿鞋就钻心地痒,上班不敢脱鞋,不能挠,工作都没发专注。

最可怕的是还会脱皮、化脓……连家人看了都嫌弃,在外脱鞋严重影响个人形象。
关键是脚气还会传染,一人得脚气,全家都感染~
而Clean-n-Fresh的这款除臭鞋球不仅使用方便,而且能从源头抑菌。
通过SGS检测,抑菌率高达99%,产品认证:有较强的抑菌作用。

通过SGS检测,抑菌率高达99%,产品认证:有较强的抑菌作用。
如此厉害是因为除臭球内置棉球中含有中成药原料——茶多酚,具有天然的除臭抑菌特性:
茶多酚中类黄酮物质具有除*作臭**用。
茶多酚可排除过量的乳酸,清楚自由基。
茶多酚可加快有害物质分解速度。
……

口说无凭,来看一下这款除臭鞋球的抑菌对比实验!
我们将放了一晚“除臭鞋球”的鞋子,与未放鞋球的鞋子,做了菌落数量对比实验。
可以明显看到放入除臭鞋球的培养皿细菌几乎为0,而没放入密密麻麻的细菌简直让强逼症发作……
将茶多酚这种抑菌成分应用在除臭球上,能持久有效破坏鞋内细菌群,抑制细菌增长,从源头除臭。
鞋子干净,双脚不用再窝在细菌堆里,干爽、舒适~

使用起来也简单,它的形状大小和一个乒乓球差不多,只要轻轻一拧出现缝隙,就能释放除味因子。

直接放在鞋子里就能抑菌除臭,不用时再拿出,不伤鞋,也不用二次清洁。
一般情况下,放在鞋内静置24小时就能起到很好的除臭效果。
点击下面小程序即可购买
不仅抑菌,还要飘香
国际大牌青睐香调
作为臭味重灾区的鞋袜,光是抑菌除味还不够,最好还能散发阵阵幽香~
这款除臭球采用的可不是普通香调,而是来自法国曼氏的精选香调。

法国曼氏作为全球著名的十大香精香料公司之一,始创于1871年,至今已有149年的历史。
在32个国家设有分部约有4750多名员工,公司全球共有25个生产基地,42个研发中心。

很多国际大牌都是由它家供应香精原料,一线大牌的选择,可见其实力之雄厚。
因此使用这款除臭球后,不仅能保持鞋内清新干爽,还能散发阵阵幽香~
该怎么形容这种香味呢?像是刚洗好的衣服那种沁人心脾的舒爽气息,有一种淡淡的亚麻清香,干净,好闻~

无论是运动打球后大汗淋漓的臭鞋,还是雨天湿鞋后的发霉发臭,放上一颗,第二天连袜子都是香香的~

而且这款除臭鞋球的成分很安全稳定,热贮性好,为此还通过SGS专业机构检测:
| 于-5℃冰箱中放置48h,取出恢复至室温观察,外观、香味无变化,内芯无悬浮物、无异味。
| 于40℃恒温箱放置48h,取出恢复至室温观察,外观、香味无变化,内芯无悬浮物、无异味。

这意味着无论是30℃+的酷暑天,还是-5℃的寒冬腊月,都能放心无忧使用。

小巧便携,即拧即用
厕所、衣柜、汽车都能用
这款除臭鞋球好用还不贵,一盒里面就有4个。
单个只有乒乓球大小,上手很轻,很便携。

使用前,只需轻轻一拧出现缝隙,即可使用。

可以把它放在任何你想要的除臭消味的地方,雪地靴、球鞋、皮鞋、马丁靴……放一颗脚臭味说拜拜~

像家里的各种箱箱柜柜,杂物存放处也很需要,梅雨时间也能保持干爽清新。
衣柜,潮湿发霉的重灾区↓

杂物篮,杂乱零细最难整理↓

书架,纸张书页易潮长黑点↓

此外像厕所、私家车等小空间也能放上一颗,抑菌除臭无死角。

而且小小一个,还能随身携带,放在背包、行李箱里,淡淡的植物香气,除臭抑菌同时,闻着也心情好

国际家居品牌
一颗,可用45天
从它能选择国际大牌香精供应商,可见一斑这个品牌的实力。
Clean-n-Fresh创始于美国,是一个专业的家居清洁品牌,48年来畅销于南美、北美,受到消费者认可。

2018年Clean-n-Fresh进入中国市场,目前已经在国内设立5个生产研发基地。
不仅拥有GMPC生产车间,更是通过了多家国际权威机构认证,符合欧盟进口标准。

产品质量有保证,因此别看它小小一个,但是单颗就能用45天之久。

而且不用时,还能旋转关闭,延长使用寿命,平时家里备多两盒,不仅除脚臭,全屋各角落都能用,简直就是居家必备。

小巧方便随身携带,平时遇上出差、旅游之类,和同事、朋友同住,脱鞋后立马放上两颗,摆脱尴尬困扰。

这一款除臭抑菌神器,现在商城还推出上新优惠活动,一物多用的“除臭抑菌”神器,小东西,提升大大幸福感。
1盒(4颗)仅需39.9元
2盒(8颗)仅需74.9元,立减5元
4盒(16颗)仅需149.9元,立减10元
dura MOBI “蜂鸟”骨传导音箱
NDIMOA多功能工具钳
防雾眼镜布
PharmaLine止鼾喷雾
